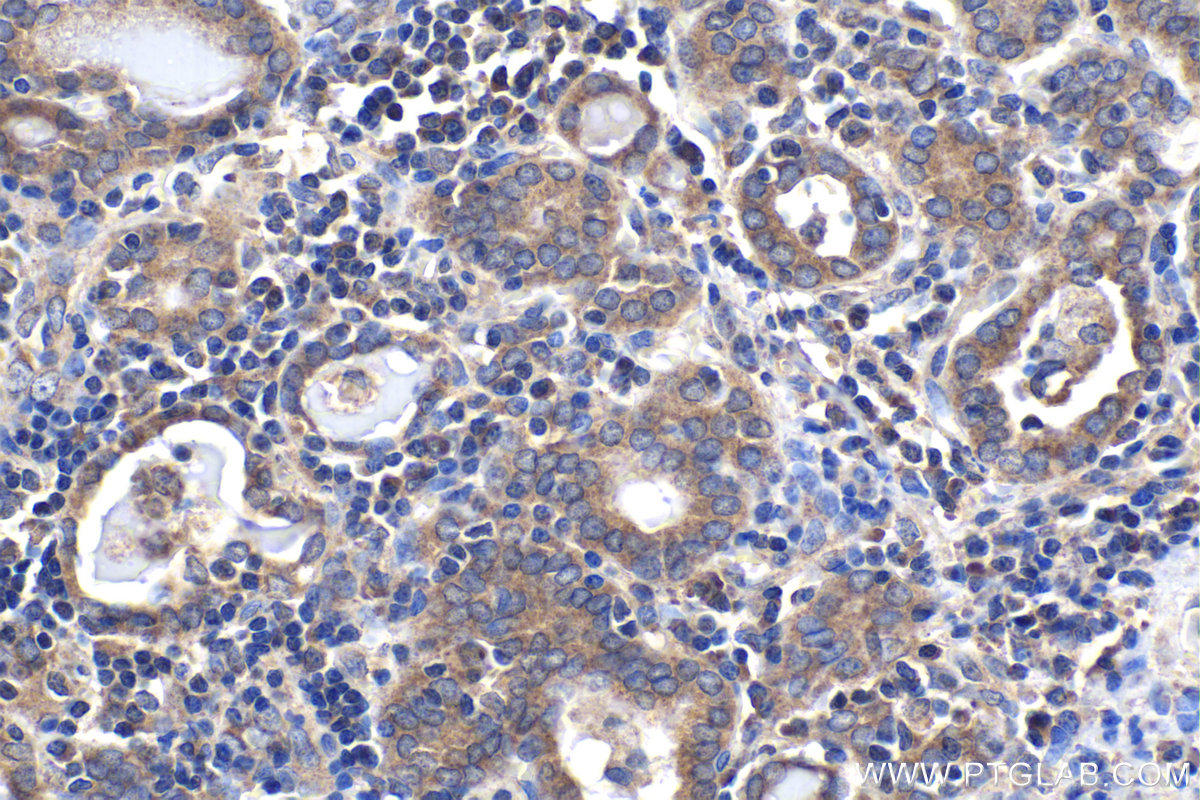

IHCeasy® RBFOX1/A2BP1 Ready-To-Use IHC Kit
RBFOX1/A2BP1 Ready-to-use reagent kit for IHC.
Reactivity
Human, Mouse
Sample Type
FFPE tissue
Cat no : KHC1966
Synonyms
A2BP, A2BP1, ataxin 2 binding protein 1, Fox 1 homolog A, FOX1, HRNBP1, RBFOX1
Validation Data Gallery
Product Information
KHC1966 is a ready-to-use IHC kit for staining of RBFOX1/A2BP1. The kit provides all reagents, from antigen retrieval to cover slip mounting, that require little to no diluting or handling prior to use. Simply apply the reagents to your sample slide according to the protocol and you're steps away from obtaining high-quality IHC data.
| Product name | IHCeasy RBFOX1/A2BP1 Ready-To-Use IHC Kit |
| Sample type | FFPE tissue |
| Assay type | Immunohistochemistry |
| Primary antibody type | Rabbit Polyclonal |
| Secondary antibody type | Polymer-HRP-Goat anti-Rabbit |
| Reactivity | Human, Mouse |
Kit components
| Component | Size | Concentration |
|---|---|---|
| Antigen Retrieval Buffer | 100 mL | 50× |
| Washing Buffer | 100 mL ×2 | 20× |
| Blocking Buffer | 5 mL | RTU |
| Primary Antibody | 5 mL | RTU |
| Secondary Antibody | 5 mL | RTU |
| Chromogen Component A | 0.2 mL | RTU |
| Chromogen Component B | 4 mL | RTU |
| Signal Enhancer | 5 mL | RTU |
| Counter Staining Reagent | 5 mL | RTU |
| Mounting Media | 5 mL | RTU |
| Datasheet | 1 Copy | |
| Manual | 1 Copy |
Background Information
A2BP1, also named as FOX1 and HRNBP1, contains one RRM (RNA recognition motif) domain. A2BP1 recognizes a (U)GCAUG stretch in regulated exons or in flanking introns. The protein binds to the C-terminus of ataxin-2 and may contribute to the restricted pathology of spinocerebellar ataxia type 2 (SCA2). Ataxin-2 is the product of the SCA2 gene which causes familial neurodegenerative diseases. A2BP1 and ataxin-2 are both localized in the trans-Golgi network.
Properties
| Storage Instructions | All the reagents are stored at 2-8°C. The kit is stable for 6 months from the date of receipt. |
| Synonyms | A2BP, A2BP1, ataxin 2 binding protein 1, Fox 1 homolog A, FOX1, HRNBP1, RBFOX1 |